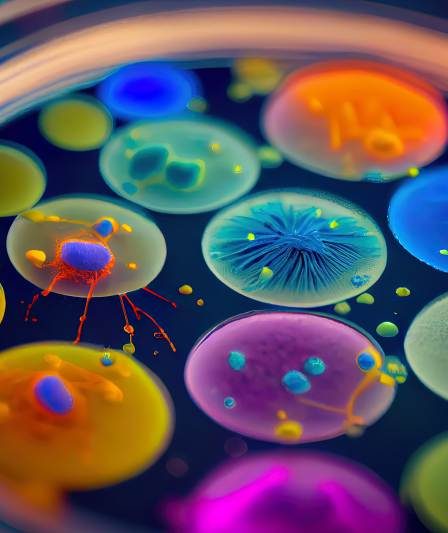

Osoba z bakteryjnym zapaleniem płuc zazwyczaj przestaje zarażać po około 24 godzinach od skutecznego rozpoczęcia antybiotykoterapii, jeśli zastosowany lek jest odpowiedni wobec patogenu i choroba nie przebiega u osób z upośledzoną odpornością. Co decyduje o zaraźliwości Zaraźliwość w zapaleniu płuc nie jest jednym, stałym parametrem — zależy od trzech głównych czynników: od rodzaju patogenu, od …
Ranny przegląd stężeń PM – jak prawidłowo interpretować alerty smogowe
Poranny przegląd stężeń powietrza i prawidłowa interpretacja alertów smogowych to umiejętność przydatna każdego dnia — szczególnie w sezonie grzewczym. Poniżej znajdziesz uporządkowane wyjaśnienia, konkretne liczby, praktyczne procedury i wskazówki, które ułatwią szybkie i bezpieczne decyzje rano. Główne punkty, które omówię co to są PM10 i PM2,5 oraz jakie mają znaczenie, normy i progi alarmowe w …
Gruszki w szarlotce — nowe oblicze klasycznego wypieku
Szarlotka z gruszkami to deser o słodszej nucie, zwartej strukturze owoców i intensywniejszej karmelizacji cukrów niż tradycyjna szarlotka z jabłek. Dlaczego gruszki zamiast jabłek Skład i wartości odżywcze Gruszki zawierają około 57 kcal na 100 g, około 3,1 g błonnika i około 10 g cukrów na 100 g (dane USDA), podczas gdy jabłka mają około …
Przepis na perfekcyjne korzenne ciasteczka na świąteczny stół
Przepis podstawowy: 300 g mąki pszennej, 150 g masła, 100 g cukru pudru, 1 jajko, 2 łyżki miodu, 1 łyżeczka proszku do pieczenia, 2 łyżeczki przyprawy korzennej (cynamon, imbir, goździki), 1/2 łyżeczki soli. Korzenne ciasteczka to klasyka świątecznego stołu w Polsce — pachną cynamonem, imbirem i miodem, a jednocześnie są prostym i uniwersalnym wypiekiem, który …
Mikroskopijni sojusznicy onkologa – jak bakteriofagi wykrywają to, czego nie widzi MRI
Krótka odpowiedź Bakteriofagi potrafią wykrywać biomarkery nowotworowe z czułością do 1000 razy większą niż standardowe obrazowanie MRI, dzięki selektywnemu wiązaniu, amplifikacji sygnału i integracji z technikami molekularnymi takimi jak PCR cyfrowy czy sekwencjonowanie. To sprawia, że można identyfikować mutacje i podtypy raka na etapie molekularnym, zanim zmiany staną się widoczne anatomicznie. Czym są bakteriofagi? Bakteriofagi …
Antydepresyjne leki bez ryzyka przybierania na wadze – czy to realne?
O co chodzi z antydepresantami? Przemierzając świat farmaceutyki, gdzie mikrogramy substancji czynnej mogą zmieniać życie, natrafiamy na leki antydepresyjne, które dla wielu osób są nieocenionym wsparciem w walce z pochmurnymi chmurami depresji. Swoistą latarnią morską, pomagającą odnaleźć się w burzliwych wodach codziennych zmagań, są one – od lat – jednymi z najczęściej przepisywanych lekarstw na …
Historia, symbolika i znani przedstawiciele imienia Jarosław – daty obchodzenia imienin
Korzenie i znaczenie imienia Jarosław Jarosław, imię o głęboko zakorzenionej historii i bogatej symbolice, od wieków fascynuje lingwistów, historyków oraz entuzjastów kultury słowiańskiej. To wyjątkowe, dwuczłonowe imię jest syntezą słów „jary”, co można tłumaczyć jako „silny, potężny, witalny” oraz „sława”, która niesie ze sobą konotacje związane z reputacją, chwałą i uznaniem. Kiedy próbuje się zrozumieć, …
Iga – historia, etymologia, daty obchodzenia oraz słynne postacie
Początki tajemnicy imienia Iga Iga – krótkie, ale niezwykle intrygujące imię, które w swojej prostocie skrywa wiele historii i sekretów, które być może nie są oczywiste na pierwszy rzut oka. Narodziny tego niebanalnego imienia mogą sięgać czasów starożytnych, kiedy to kultury zaczynały nadawać imiona nie tylko dla ułatwienia komunikacji, ale też jako sposób na wyrażenie …
Historia i znaczenie imienia Cecylia – pochodzenie, daty imienin oraz znane postaci
Pochodzenie i znaczenie imienia Cecylia Wędrując po nieprzebytych ścieżkach historii imion, zatrzymujemy się przy imieniu Cecylia, które otacza aura dostojności i delikatności jednocześnie, a jego korzenie sięgają starożytnego Rzymu. Imię to wywodzi się od łacińskiego słowa „caecus”, co znaczy „ślepy”. Jednakże z upływem lat obrosło w nowe, bardziej pozytywne konotacje, związane z bogactwem i szlachectwem, …
Badanie Komórek – Analiza Cytologiczna
Fascynujący świat analizy cytologicznej Badanie komórek, choć może wydawać się skomplikowane, jest fascynującą dziedziną nauki, która otwiera przed nami drzwi do zrozumienia tajemnic życia na poziomie mikroskopijnym. Wyobraź sobie, że każdy, na pozór nieistotny, fragment naszego ciała to świat pełen niezwykłych, niewidocznych gołym okiem struktur. Analiza cytologiczna pozwala nam zgłębić te maleńkie ekosystemy, składające się …